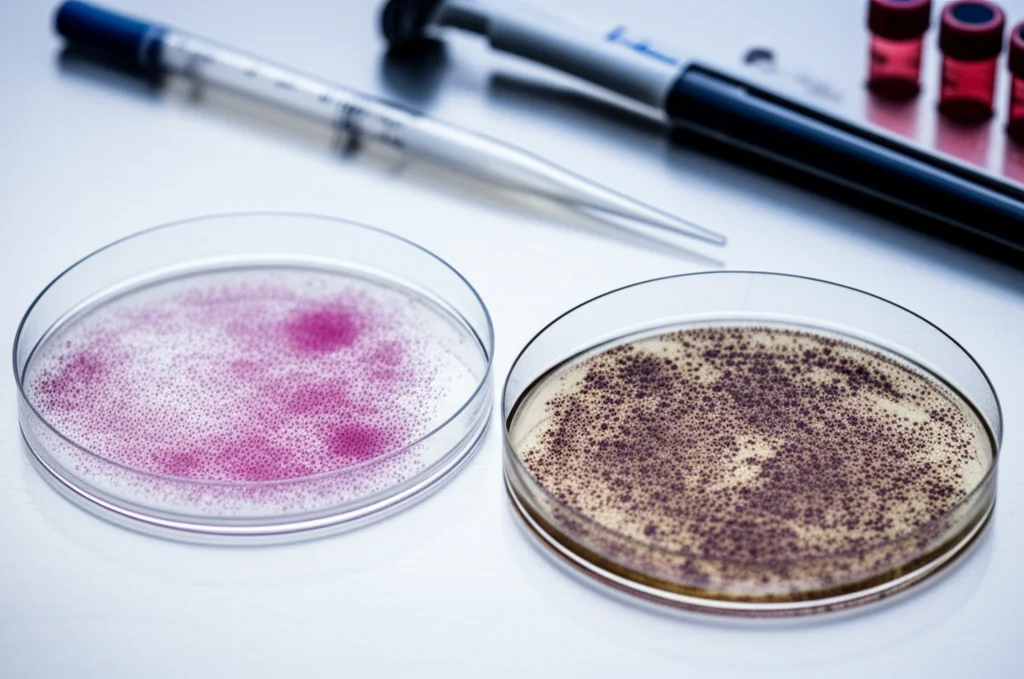
Due piastre Petri da laboratorio viste dall'alto, una contenente cellule epatiche umane sane e l'altra cellule simili trattate con un estratto vegetale scuro, mostrando segni di citotossicità. Illuminazione da laboratorio, nitida e clinica. Obiettivo da 50mm, profondità di campo media per mantenere a fuoco entrambe le piastre. Accanto, una pipetta e provette.

Artemisia contro la Malaria Resistente: Amica o Nemica Nascosta nelle Nostre Tazze?
Ciao a tutti, appassionati di scienza e curiosi! Oggi voglio portarvi con me in un viaggio affascinante e un po’ preoccupante nel mondo della fitoterapia e della lotta a una delle malattie più ostinate del pianeta: la malaria. Sapete, da tempo immemore l’uomo si affida alle piante per curarsi, e l’Artemisia è una di quelle che da secoli fa parlare di sé, soprattutto in Africa, come rimedio contro la malaria. Ma cosa succede quando il nemico, il parassita della malaria, diventa più furbo e resistente ai farmaci tradizionali, inclusa l’artemisinina, il principio attivo star estratto proprio da una specie di Artemisia? È una domanda che ci siamo posti in tanti, e uno studio recente ha cercato di fare un po’ di luce, con risultati che, ve lo dico subito, mi hanno fatto riflettere parecchio.
La Sfida: Malaria Resistente e Rimedi della Nonna
Immaginate la scena: in molte parti dell’Africa, la gente prepara infusi, delle vere e proprie tisane, con due tipi principali di Artemisia: l’Artemisia annua (quella più famosa per l’artemisinina) e l’Artemisia afra. La speranza è che queste bevande possano tenere a bada la malaria. Il problema è che, soprattutto di recente, abbiamo visto emergere in Africa ceppi di Plasmodium falciparum, il parassita della malaria, che se ne fregano dell’artemisinina. Questa resistenza è un campanello d’allarme enorme, perché potrebbe compromettere l’efficacia delle terapie combinate a base di artemisinina (le famose ACT), che sono la nostra arma principale.
Qualcuno ha ipotizzato che l’uso diffuso e non standardizzato di queste tisane potrebbe addirittura contribuire a selezionare parassiti resistenti. Pensateci: una tisana fatta in casa non avrà mai una dose precisa di principi attivi, e questo potrebbe “allenare” i parassiti a sopravvivere. D’altro canto, i sostenitori di queste fitoterapie dicono: “Ehi, ma la pianta intera è una poli-chemioterapia naturale! Ci sono un sacco di altre sostanze che lavorano insieme e limitano la resistenza”. Studi su modelli animali sembravano dare qualche speranza in questo senso. Ma cosa succede davvero con i parassiti umani, quelli resistenti che ci preoccupano tanto?
Cosa Abbiamo Scoperto in Laboratorio?
Per capirci qualcosa di più, i ricercatori hanno preso degli estratti acquosi di Artemisia annua e Artemisia afra – proprio come se stessimo preparando una tisana – e li hanno testati in laboratorio. Hanno usato ceppi clinici di Plasmodium falciparum raccolti in Cambogia, alcuni sensibili all’artemisinina e altri, ahimè, resistenti, con specifiche mutazioni nel gene Pfkelch13 (segnatevi questo nome, è il colpevole genetico della resistenza). L’idea era vedere se questi parassiti resistenti riuscissero a sopravvivere meglio all’esposizione agli estratti. E, cosa fondamentale, hanno anche controllato quanto questi estratti fossero tossici per le cellule umane, in particolare per le cellule del fegato (epatociti primari umani e una linea cellulare chiamata HepG2), perché un rimedio deve far male al parassita, non a noi!
Artemisia annua: Una Brutta Sorpresa (o Forse No?)
Partiamo dall’Artemisia annua. I risultati sono stati piuttosto chiari, e non proprio incoraggianti. Gli estratti di A. annua si sono dimostrati nettamente meno efficaci contro i parassiti resistenti all’artemisinina rispetto a quelli sensibili. In pratica, per fermare i parassiti resistenti serviva una concentrazione di estratto molto più alta. E indovinate un po’? L’attività dell’A. annua sembrava proprio legata al suo contenuto di artemisinina. Questo significa che usare tisane di A. annua potrebbe, di fatto, favorire la selezione di parassiti resistenti, proprio come l’uso non corretto dei farmaci a base di artemisinina. Non sembra quindi che ci siano vantaggi farmacologici particolari rispetto alle terapie standard, anzi!
Qualcuno potrebbe obiettare che studi su animali hanno mostrato una maggiore concentrazione di artemisinina nel sangue grazie ad altre molecole presenti nella pianta. Vero, ma dati clinici sull’uomo suggeriscono che concentrazioni più alte di derivati dell’artemisinina non si traducono necessariamente in una più rapida eliminazione dei parassiti, né sensibili né resistenti. Quindi, il rischio di selezionare resistenza con l’A. annua in tisana sembra concreto.

Artemisia afra: Un Quadro Più Complesso e Preoccupante
E l’Artemisia afra? Qui la storia si fa diversa, e per certi versi ancora più ingarbugliata. Gli estratti di A. afra hanno mostrato un’attività interessante contro tutti i ceppi di parassiti testati, sia quelli sensibili che quelli resistenti all’artemisinina. E non sembrava esserci una correlazione con la resistenza alla diidroartemisinina (DHA, un metabolita dell’artemisinina). Questo è coerente con il fatto che l’A. afra contiene pochissima artemisinina. Quindi, l’A. afra sembra combattere la malaria con armi diverse, non basate sull’artemisinina. “Ottimo!”, direte voi. Beh, non così in fretta.
Il primo problema è che non sappiamo quali siano queste “armi segrete”. Si è parlato di flavonoidi, ma la vera natura dell’attività antimalarica degli estratti acquosi di A. afra è ancora un mistero. E poi c’è un altro aspetto cruciale: l’attività antimalarica che abbiamo visto in laboratorio si manifestava a dosi piuttosto alte, dosi che difficilmente si raggiungerebbero bevendo una normale tisana.
Ma la vera doccia fredda è arrivata quando abbiamo guardato la tossicità. Sebbene entrambe le piante abbiano mostrato una certa tossicità sulle cellule HepG2 (cosa in parte attesa per l’A. annua, dato che l’artemisinina ha anche effetti anti-tumorali), la situazione con gli epatociti primari umani è stata diversa. Gli estratti acquosi di A. afra si sono rivelati marcatamente più tossici per queste cellule rispetto a quelli di A. annua. Questo è un bel problema!
Il Dilemma della Selettività: Uccidere il Parassita, Non Noi!
Per valutare meglio questo aspetto, si usa un parametro chiamato “indice di selettività”. In parole povere, ci dice quanto un estratto è più tossico per il parassita rispetto alle nostre cellule. Un indice alto è buono (molto tossico per il parassita, poco per noi), un indice basso è preoccupante.
Ebbene, per l’A. annua, l’indice di selettività era piuttosto alto, soprattutto contro i parassiti sensibili. Ma per l’A. afra, gli indici erano decisamente bassi (tra 4 e 6 circa). Questo significa che la “finestra terapeutica”, cioè la differenza tra la dose che uccide il parassita e quella che danneggia le nostre cellule, è piuttosto stretta. E questo solleva seri dubbi sulla sicurezza dell’uso dell’A. afra.
È vero che studi precedenti avevano riportato bassa tossicità per questi estratti su epatociti umani e di scimmia, ma le differenze potrebbero essere dovute alla variabilità tra i donatori di cellule. In ogni caso, questi dati sulla tossicità non possono essere ignorati. Ci sono stati anche casi riportati di eventi avversi legati al consumo di tisane di Artemisia. Forse le stesse sostanze che combattono la malaria nell’A. afra sono anche quelle responsabili della sua tossicità.
Conclusioni (Amare) e Prospettive Future
Quindi, cosa ci portiamo a casa da questo studio? Diverse preoccupazioni, a dire il vero.
- L’uso dell’Artemisia annua come surrogato antimalarico, soprattutto sotto forma di tisana, potrebbe non solo essere inefficace contro i ceppi resistenti, ma addirittura facilitare la selezione e l’emergenza di parassiti resistenti all’artemisinina. Non proprio una buona notizia.
- L’Artemisia afra, pur mostrando un’attività antimalarica indipendente dall’artemisinina e attiva anche contro i ceppi resistenti, solleva seri interrogativi sulla sua sicurezza a causa della bassa selettività e della potenziale tossicità epatica. Le sue “armi segrete” potrebbero essere un’arma a doppio taglio.
Tutto questo, unito alla mancanza di dati concreti sull’efficacia in vivo di queste fitoterapie (cioè, nelle persone malate, non solo in provetta) e ai problemi di standardizzazione delle preparazioni casalinghe, ci porta a rinnovare una certa cautela. Non sto dicendo che la fitoterapia sia da buttare, anzi! La natura è una fonte incredibile di molecole attive. Ma è fondamentale indagare a fondo, capire i meccanismi, valutare l’efficacia e, soprattutto, la sicurezza.
La lotta alla malaria è una maratona, non uno sprint, e ogni arma potenziale va esaminata con rigore scientifico. Forse nell’Artemisia afra si nasconde davvero un composto antimalarico innovativo, ma prima di consigliarne l’uso indiscriminato, c’è ancora tanta strada da fare per isolarlo, caratterizzarlo e assicurarsi che sia sicuro ed efficace. Nel frattempo, affidiamoci alle terapie validate e continuiamo a cercare, con la mente aperta ma con i piedi ben piantati nella scienza.
Fonte: Springer
